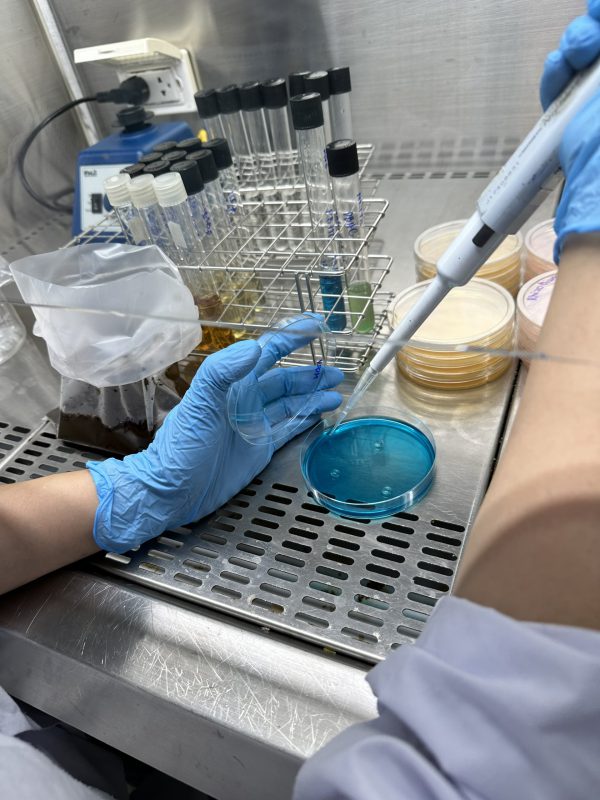

Ngày 19/4/2024 Trung tâm Nghiên cứu và Ứng dụng Công nghệ sinh học phối hợp cùng Công ty Cổ phần Công nghệ Vietlabs tổ chức khai giảng khóa đào tạo “Kiểm tra chất lượng vi sinh vật trong sản phẩm phân bón hữu cơ vi sinh” tại Công ty Cổ phần Công nghệ Vietlabs.
Buổi khai giảng có sự tham gia đào tạo của cả 2 bên đơn vị gồm có:
- ThS. Nguyễn Văn Minh – Giám đốc TT Nghiên cứu và ứng dụng CNSH Trường ĐH Mở TPHCM
- ThS. Dương Nhật Linh – Giảng viên Khoa CNSH Trường ĐH Mở TPHCM
- ThS. Hoàng Tường Vi – Giám đốc chất lượng Vietlabs
- CN. Lê Thùy Quyên – Trưởng phòng Vi sinh Vietlabs
Xem thêm:
- Sinh viên Trường Đại học Mở Thành phố Hồ Chí Minh đạt nhiều thành tích tại Giải thưởng Sinh viên Nghiên cứu Khoa học Euréka lần thứ 25
- Khai giảng khóa đào tạo: Kiểm tra chất lượng vi sinh vật trong sản phẩm phân bón hữu cơ vi sinh
- Tham Quan Tập Đoàn Mỹ Lan
- QA/QC Ra Đời Như Thế Nào?
- Lễ Ký Kết Chương Trình Co-Op Với Tập Đoàn Agris